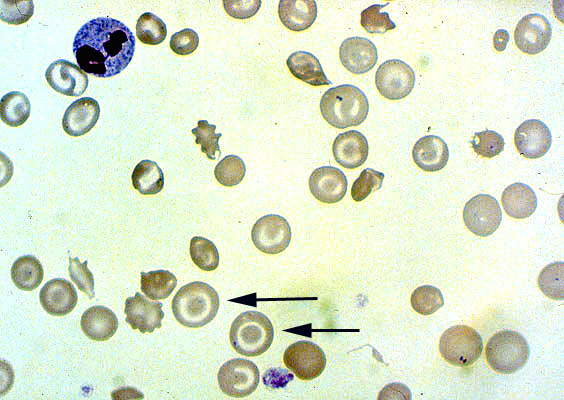

Target red blood cells, peripheral blood smear
Click picture to enlarge. Close window to return
Target RBCs appear like a "bulls eye", and are formed by red cells with a relative excess of membrane. They are seen in thalassemia, some hemoglobinopathies and liver disease, as well as other disorders.